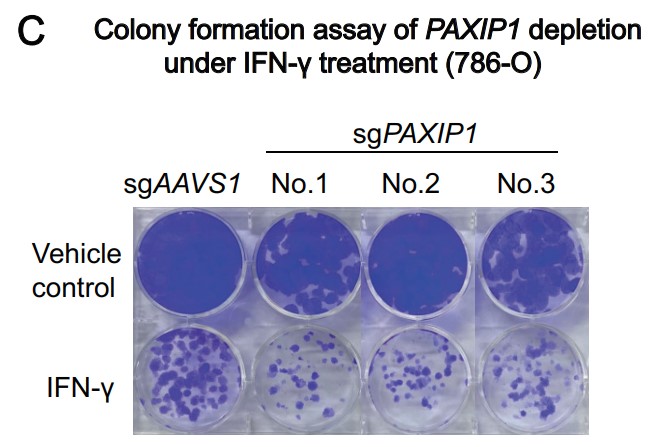
CIR_AACR's tweet image. New for the March issue—
#CancerCell Resistance to IFNγ Can Occur via Enhanced Double-Strand Break Repair Pathway Activity, by Tong Han, Xujun Wang, Peng Zhang, Chenfei Wang et al.
bit.ly/3lbvkzu
@Wubing44589261

#cancercell search results
Evilab presenting at cancer cell immunity conference in Sitges! @ICR_London #cancercell #immunity #Immunotherapy

Anti-Cancer Mechanisms of Small Molecule Drugs Predicted by DeepTarget DeepTarget is a computational tool that integrates large-scale drug screens with #omics data to predict mechanisms of #cancercell killing @Sanjusinha7 @sbpdiscovery #anticancerdrugs hubs.li/Q03TM_WH0
#Scientists are ready for a #surgicalstrike in #cancercell to explore anti-cancer drug inside the body. During #GUJCOST organized #STI Ecosystem for #Societal Development, Dr Sudipta Basu @iitgn presented the societal implication of project funded under #STIPolicy of #Gujarat.



"Shape-Shifting" Cancer Cells Reveal How Tumors Invade Dense Tissue #Cancercell deformability enhances movement through tight spaces but has minimal impact on directional choices during confined migration @KavliFoundation #tumors #metastasis hubs.li/Q03VvMHC0
Brain tumors exploit body's daily rhythms to fuel growth. #CancerCell "Daily glucocorticoids promote glioblastoma growth and circadian synchrony to the host"

Germany: सर्जरी के दौरान डॉक्टर को मरीज से ही हो गया कैंसर ◆ कैंसर मरीज के ऑपरेशन के दौरान उंगली में लगे कट के जरिए मरीज की कैंसर सेल उनके शरीर में ट्रांसफर हो गई ◆ एक्सपर्ट्स बोले अनोखा मामला, सर्जरी कर रहे डॉक्टर की इम्यूनिटी कमजोर रही होगी #ViralStory #CancerCell

Our commentary on Precision oncology across the ages - @VivekSubbiah oncodaily.com/insight/134040 #Cancer #CancerCell #OncoDaily #Oncology #PrecisionOncology #Tumor

In the August issue— The transcriptional and epigenetic landscape of #cancercell lineage plasticity, by @AlistarDavies, @AminaZoubeidi, @mishabeltran, @LukeSelth et al. bit.ly/3OsXXCN @Flinders @cancerFCIC @SouthernAdlLHN @ubcscience @DanaFarber @harvardmed

🔬Signalling and Cell Cycle Laboratory. Group Leader: Dr. Ángel R. Nebreda 👉Apply if you are interested in: #p38MAPK #SignalingNetwork #CancerCell #homeostasis #ChemotherapyResistance #TumorMicroenvironment ➡️bit.ly/3IxpT6j

Interaction of an APC with a cancer cell, illustrated by Lila Strohl. Explore more of her work: buff.ly/2NoUGcq #cancercell #cancer #oncology #biotech #cellbiology #molecularbiology #medical #illustration #medicalillustration #scientificillustration #medicalillustrator

Researchers at ETH Zurich have uncovered how #Colorectal #CancerCell's colonise the liver. Their findings could open up new ways to suppress this process in the future. brnw.ch/21wLtkS @ETH_BSSE
We are hosting the CCBIR/TEC conference at Hopkins - @deniswirtz @JohnsHopkins oncodaily.com/65739.html #AcademicConference #Cancer #CancerCell #Biology #Research #TissueEngineering #CCBIR #JohnsHopkinsUniversity #NationalCancerInstitute #OncoDaily #Oncology

INCREDIBLE FOOTAGE T-cells in combat against cancer cell, with a sensor inside the cancer cell lighting up upon contact, through this, develop new treatments to strengthen the immune response against cancer. Source: Jeroen Slaats /buff.ly/3LDb2cc #cancercell #Tcells
#ICYMI from the latest issue— The transcriptional and epigenetic landscape of #cancercell lineage plasticity, by @AlistarDavies, @AminaZoubeidi, @mishabeltran, @LukeSelth et al. bit.ly/45GdHK0 @Flinders @cancerFCIC @SouthernAdlLHN @ubcscience @DanaFarber @harvardmed

#CancerCell: #TIM-3 is a highly expressed molecule in diffuse intrinsic pontine glioma (#DIPG) #tumor cells and immune microenvironment, and its blockade triggers a potent #immune response. That's to say, TIM-3 is a bona fide target in DIPG. pubmed.ncbi.nlm.nih.gov/37802053/ #Cancer

New for the March issue— #CancerCell Resistance to IFNγ Can Occur via Enhanced Double-Strand Break Repair Pathway Activity, by Tong Han, Xujun Wang, Peng Zhang, Chenfei Wang et al. bit.ly/3lbvkzu @Wubing44589261
Extremely important research on high-grade gliomas - Angela Mastronuzzi @CellPressNews oncodaily.com/insight/142246 #Cancer #CancerAwareness #CancerCell #Glioma #OncoDaily #Oncology #MedEd #MedX #MedNews #Medicine #Health

🤩🤩Wow! our customers published a paper in #CancerCell~ This study revealed the key molecular #mechanism that promotes the formation of vascular #tumor thrombus in early #bladder #cancer and provided new #targets for bladder cancer. pubmed.ncbi.nlm.nih.gov/38428409/

"Shape-Shifting" Cancer Cells Reveal How Tumors Invade Dense Tissue #Cancercell deformability enhances movement through tight spaces but has minimal impact on directional choices during confined migration @KavliFoundation #tumors #metastasis hubs.li/Q03VvMHC0
New on #CancerCell: @SYSUCC showed colorectal cancer cells can switch identity to “Paneth-like” cells under KRAS/EGFR combo pressure. SMAD1➡️FGFR3 axis drives the shift and drug escape. Targeting lineage plasticity = next-gen anti-resistance idea.#CRC #tumor




Anti-Cancer Mechanisms of Small Molecule Drugs Predicted by DeepTarget DeepTarget is a computational tool that integrates large-scale drug screens with #omics data to predict mechanisms of #cancercell killing @Sanjusinha7 @sbpdiscovery #anticancerdrugs hubs.li/Q03TM_WH0
Evilab presenting at cancer cell immunity conference in Sitges! @ICR_London #cancercell #immunity #Immunotherapy

🎉 Excited to share my first-author #publication in #CancerCell ! I’m truly grateful to my mentor @fabianaperna, collaborators, and colleagues at @MoffittNews 👉 Read the full article here: dlvr.it/TNZXLR
Beautiful cover by #CancerCell
We are enamored with Cancer Cell's September issue and hope you love it too! Read it now: cell.com/cancer-cell/is…

News That You Might Have Missed! Stay Updated With Healthwire Media #cancerworkout #cancercell #dengue #denguefever #monsoonseason #gynaecologists #irregularperiod #healthupdates #healthytips #dailynews #newsupdates #healthwiremedia



Th17 Cells and B Cell Cooperation Drive Durable Tumor Immunity - @Chrystal_Paulos oncodaily.com/blog/chrystal-… @Cancer_Cell @LesinskiLab @Dr_Muranski @WinshipAtEmory @theNCI #NCI #CancerCell #Immunotherapy #ImmuneOnc #TumorImmunity #Cancer #OncoDaily #Medicine #Oncology #MedEd…

this natural molecule pierces #cancercell membranes and disrupts their communication, making it a #unique and promising agent in #cancertherapy. #MelittinBreakthrough #BeeVenom #Eradicates #Aggressive #BreastCancer #BreastCancerCells #InMinutes #PotentiallyLifeChaning #Think
Alat Tes Urine Deteksi Dini Kanker Asal Jepang Beri Harapan Baru Sebuah perusahaan rintisan asal Jepang mengembangkan alat tes kanker untuk deteksi dini pada tahap awal. Baca Selengkapnya:👇 leegaylord.com/alat-tes-urine… #craif #Cancer #cancercell #cancerresearch #Cancercure #Japan
leegaylord.com
Alat Tes Urine Deteksi Dini Kanker Asal Jepang Beri Harapan Baru
Sebuah perusahaan rintisan asal Jepang mengembangkan alat tes kanker berbasis urine untuk deteksi dini pada tahap paling awal.
This review from @CIEJZMU summarizes the roles of #EpithelialMesenchymalTransition (EMT) in #glioblastoma initiation and progression, its impact on #cancercell behavior, and the challenges of targeting EMT in therapy, highlighting potential strategies to improve treatment…

'Actin' Under The Microscope: From Fueling Cancer To Brain Disorders, A Tiny Protein's Giant Impact #Actin #IISC #CancerCell #TechNews etvbharat.com/en/!technology…
How do you map esophageal cancer evolution? Chang et al.’s latest #CancerCell publication gave us an answer—and a stunning cover spot. Let’s congratulate their achievement & read their article to see how Xenium #singlecellspatial imaging helped their work: bit.ly/4iJWoOT

Germany: सर्जरी के दौरान डॉक्टर को मरीज से ही हो गया कैंसर ◆ कैंसर मरीज के ऑपरेशन के दौरान उंगली में लगे कट के जरिए मरीज की कैंसर सेल उनके शरीर में ट्रांसफर हो गई ◆ एक्सपर्ट्स बोले अनोखा मामला, सर्जरी कर रहे डॉक्टर की इम्यूनिटी कमजोर रही होगी #ViralStory #CancerCell

#Scientists are ready for a #surgicalstrike in #cancercell to explore anti-cancer drug inside the body. During #GUJCOST organized #STI Ecosystem for #Societal Development, Dr Sudipta Basu @iitgn presented the societal implication of project funded under #STIPolicy of #Gujarat.



Interaction of an APC with a cancer cell, illustrated by Lila Strohl. Explore more of her work: buff.ly/2NoUGcq #cancercell #cancer #oncology #biotech #cellbiology #molecularbiology #medical #illustration #medicalillustration #scientificillustration #medicalillustrator

Evilab presenting at cancer cell immunity conference in Sitges! @ICR_London #cancercell #immunity #Immunotherapy

In the August issue— The transcriptional and epigenetic landscape of #cancercell lineage plasticity, by @AlistarDavies, @AminaZoubeidi, @mishabeltran, @LukeSelth et al. bit.ly/3OsXXCN @Flinders @cancerFCIC @SouthernAdlLHN @ubcscience @DanaFarber @harvardmed

Cover illustration of a cancer cell by @ShoemakerMed for a manuscript in Chemistry and Biology, commissioned by Agios Pharmaceuticals. Explore more: buff.ly/319miqp #cancercell #cellbiology #coverart #editorialillustration #oncology #3D #medicalillustration #sciart

Cover art by @ShoemakerMed for a manuscript in Chemistry and Biology, commissioned by Agios Pharmaceuticals. Explore more work by Shoemaker Medical: buff.ly/319miqp #cancercell #oncoloby #pharmacology #medical #illustration #medicalillustration #scientificillustration

Our commentary on Precision oncology across the ages - @VivekSubbiah oncodaily.com/insight/134040 #Cancer #CancerCell #OncoDaily #Oncology #PrecisionOncology #Tumor

Cells at work fandom is more dead than any fandom I’ve seen or have been into help #wbc1146 #cancercell #hatarakusaibou

We are hosting the CCBIR/TEC conference at Hopkins - @deniswirtz @JohnsHopkins oncodaily.com/65739.html #AcademicConference #Cancer #CancerCell #Biology #Research #TissueEngineering #CCBIR #JohnsHopkinsUniversity #NationalCancerInstitute #OncoDaily #Oncology

🔬Signalling and Cell Cycle Laboratory. Group Leader: Dr. Ángel R. Nebreda 👉Apply if you are interested in: #p38MAPK #SignalingNetwork #CancerCell #homeostasis #ChemotherapyResistance #TumorMicroenvironment ➡️bit.ly/3IxpT6j

Detecting cancer cells often involves advanced medical techniques such as biopsies, imaging tests, and blood markers. Early detection is crucial for successful treatment and improved outcomes in the fight against cancer. For More Follow Us healthreactive.com #cancercell

#ICYMI from the latest issue— The transcriptional and epigenetic landscape of #cancercell lineage plasticity, by @AlistarDavies, @AminaZoubeidi, @mishabeltran, @LukeSelth et al. bit.ly/45GdHK0 @Flinders @cancerFCIC @SouthernAdlLHN @ubcscience @DanaFarber @harvardmed

Germany: सर्जरी के दौरान डॉक्टर को मरीज से ही हो गया कैंसर ◆ कैंसर मरीज के ऑपरेशन के दौरान उंगली में लगे कट के जरिए मरीज की कैंसर सेल उनके शरीर में ट्रांसफर हो गई ◆ एक्सपर्ट्स बोले अनोखा मामला, सर्जरी कर रहे डॉक्टर की इम्यूनिटी कमजोर रही होगी #ViralStory #CancerCell

Integration of Quantitative Methods and Mathematical Approaches for the Modeling of #CancerCell Proliferation Dynamics ow.ly/jlyv50MHm0M #ArticlesInPress #review #CellDynamics #GrowthModels #MathematicalModeling @AmyBrock_PhD @UTBiomedical

New on #CancerCell: @SYSUCC showed colorectal cancer cells can switch identity to “Paneth-like” cells under KRAS/EGFR combo pressure. SMAD1➡️FGFR3 axis drives the shift and drug escape. Targeting lineage plasticity = next-gen anti-resistance idea.#CRC #tumor




El #cancer asociado a la #obesidad, ¿cuándo hay riesgo? | Un estudio publicado en la revista #CancerCell determina que tanto la acumulación general de grasa como su distribución en distintas partes del cuerpo confieren distintos riesgos de cáncer seco.org/El-cancer-asoc…

Extremely important research on high-grade gliomas - Angela Mastronuzzi @CellPressNews oncodaily.com/insight/142246 #Cancer #CancerAwareness #CancerCell #Glioma #OncoDaily #Oncology #MedEd #MedX #MedNews #Medicine #Health

Moffitt Cancer Center is at the forefront of cancer discovery - @PatrickHwuMD @MoffittNews @Cancer_Cell @ProfGregSawyer @LabElsaFlores oncodaily.com/93849.html #CancerCell #Bioengineering #Cancer #OncoDaily #Oncology #CancerAwareness #FightAgainstCancer

Strategies to promote gender equality in academia - @bentollphd @CellCellPress @muschollings @AACR oncodaily.com/94814.html #CancerCell #GenderEquality #MUSC #OncoDaily #Oncology #AACR

Something went wrong.
Something went wrong.
United States Trends
- 1. #IDontWantToOverreactBUT N/A
- 2. $ENLV 7,945 posts
- 3. #GEAT_NEWS N/A
- 4. Jimmy Cliff 16.6K posts
- 5. Thanksgiving 133K posts
- 6. #MondayMotivation 11.4K posts
- 7. Good Monday 45.8K posts
- 8. Victory Monday 3,049 posts
- 9. TOP CALL 4,576 posts
- 10. $GEAT N/A
- 11. DOGE 213K posts
- 12. Monad 154K posts
- 13. AI Alert 2,558 posts
- 14. #MondayVibes 3,078 posts
- 15. #VenezuelaVictoriaTotal 2,601 posts
- 16. The Harder They Come 2,123 posts
- 17. Market Focus 3,078 posts
- 18. Token Signal 3,053 posts
- 19. Check Analyze N/A
- 20. $NVO 3,222 posts



























































